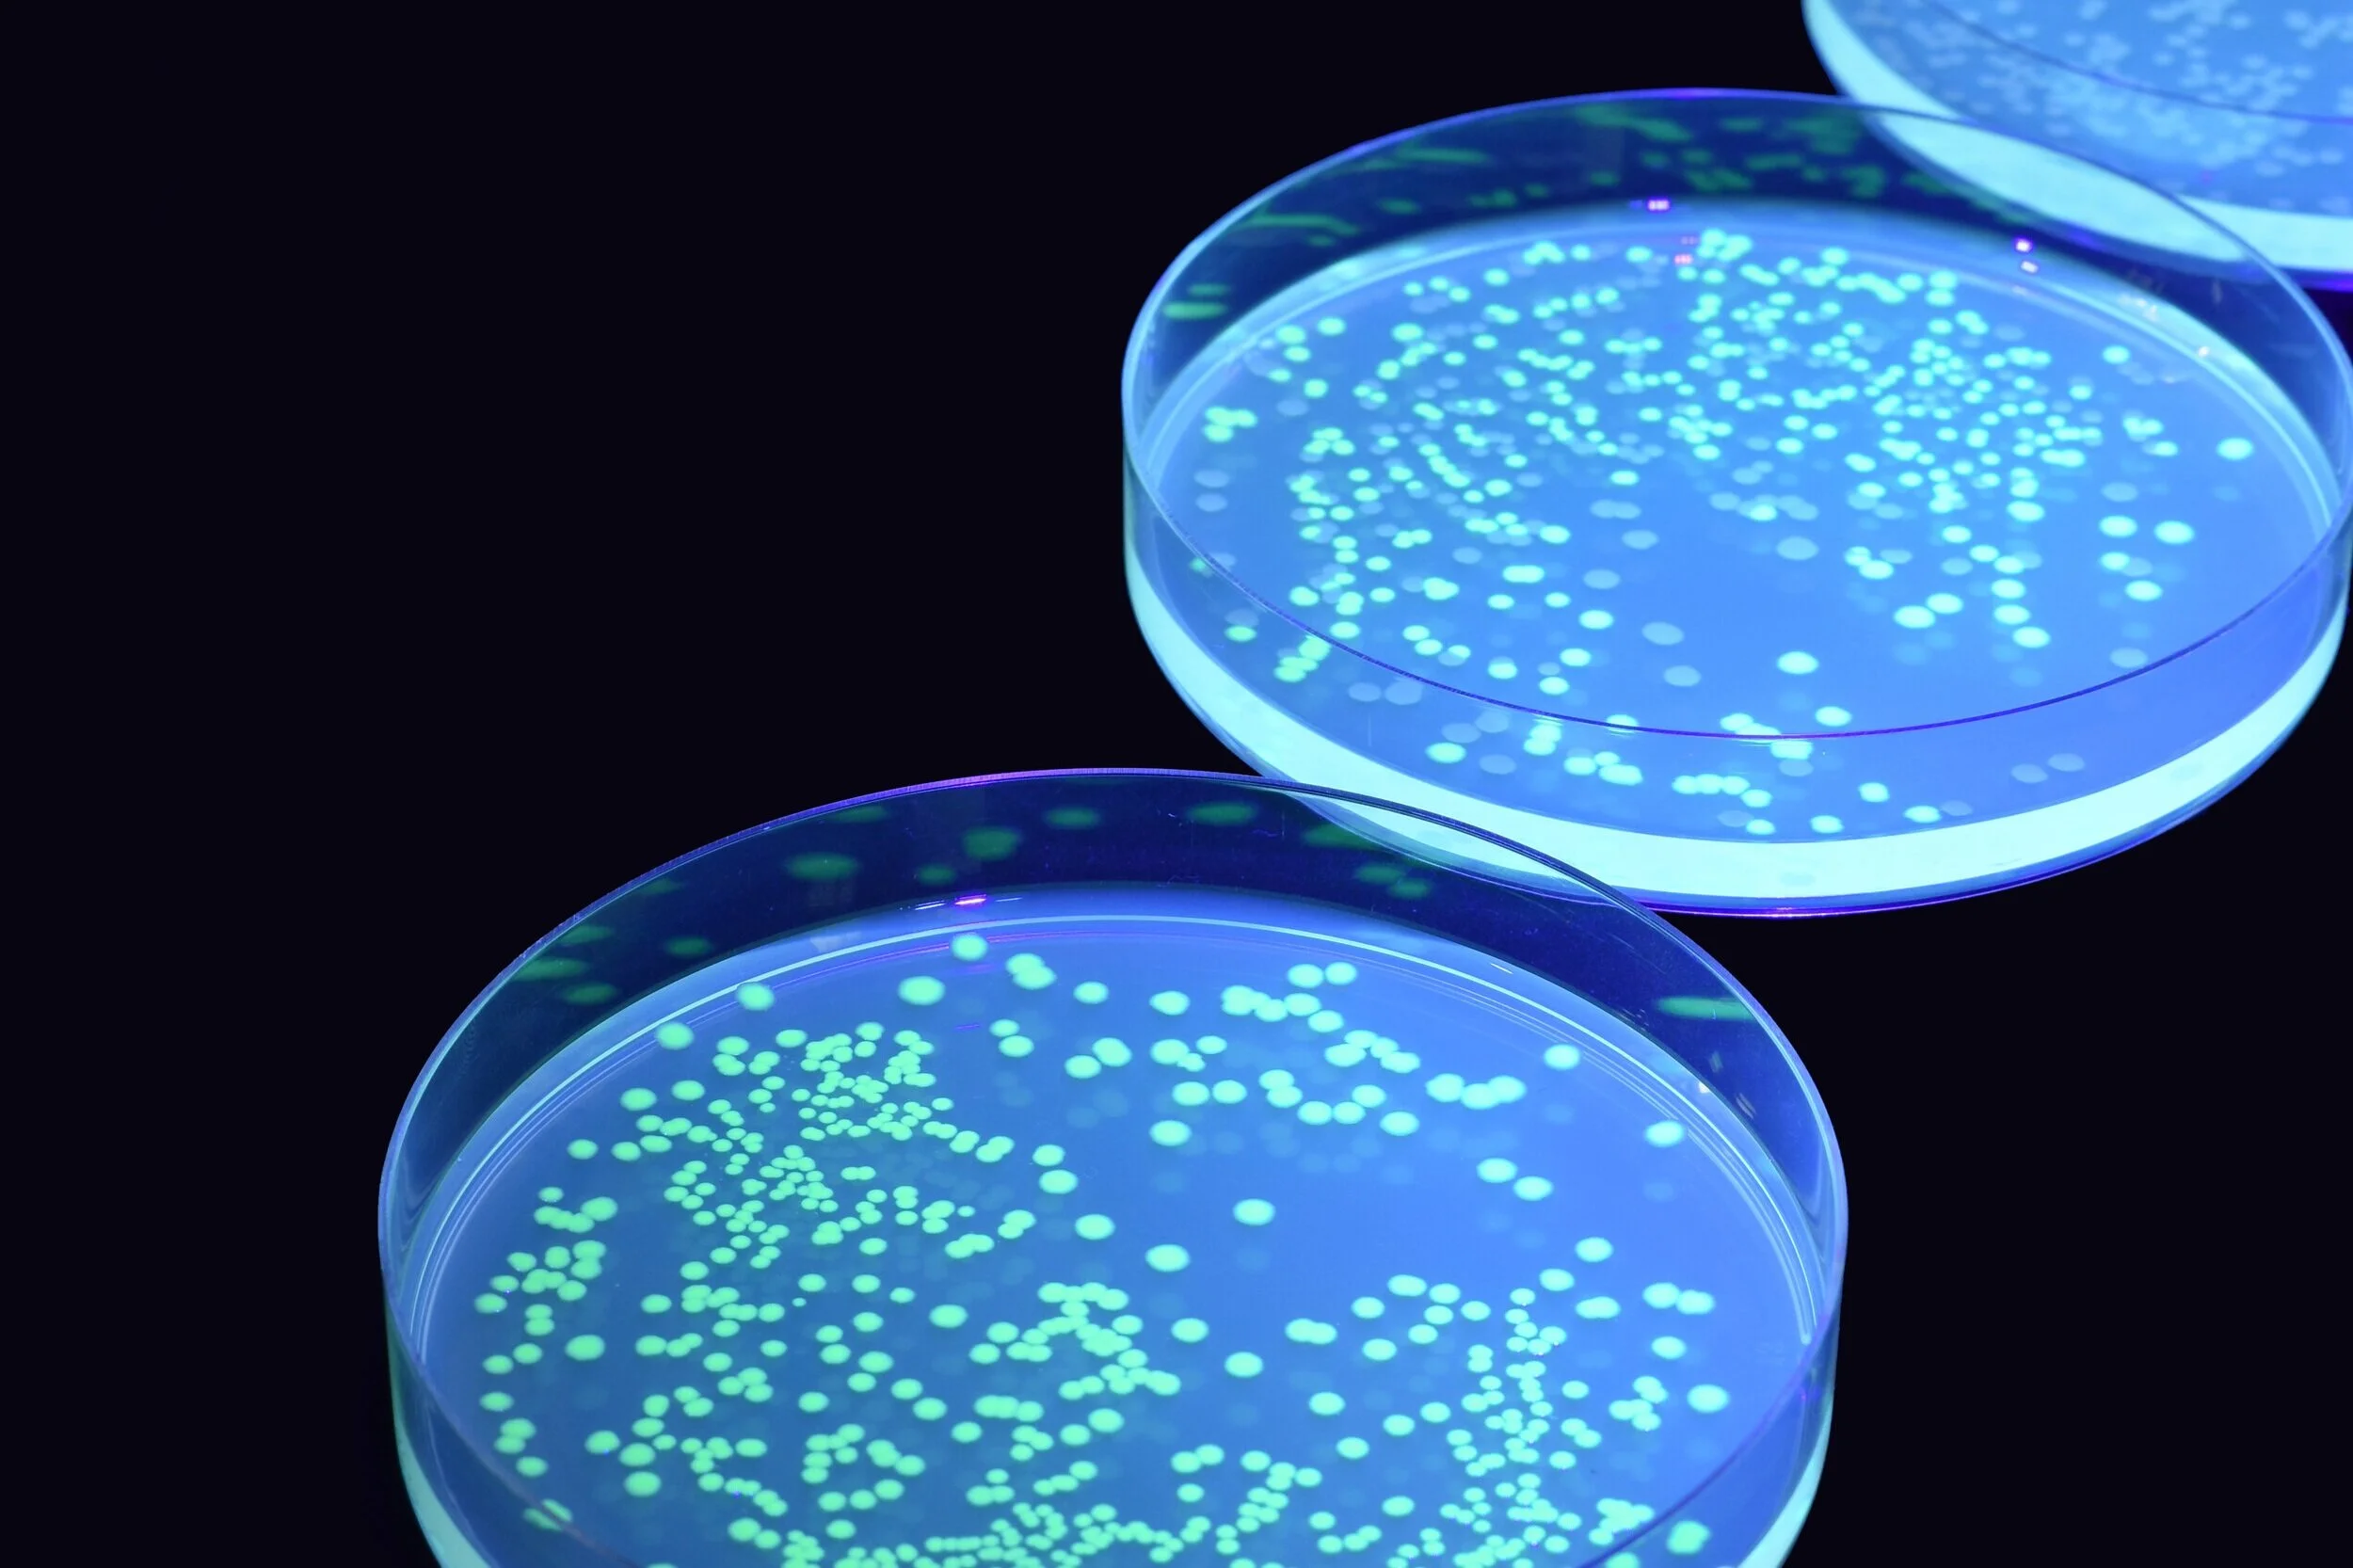

Products
Browse all Products
Everything you need to offer exciting STEM classes
We make it easy with classroom practical kits including all the resources you need to prepare and run a range of experiments. Our kits include DNA Analysis, Genetic Engineering and Microbiology.
Plus our cutting edge equipment is available for hire, allowing you to perform a range of genetic and microbiology experiments without the expense of purchasing equipment.
Choose from our categories of Biotechnology
DNA Analysis
Students learn to identify similarities and differences in DNA samples. They will load and run an agarose gel and analyse the results. We offer class kits and equipment for purchase or hire.
Electrophoresis
PCR
Genetic Engineering
Students insert a gene to produce Green Fluorescent protein in E.Coli to learn about the ability of genome modification to produce organisms with varying characteristics.
Green Fluorescent Protein
CRISPR (Coming soon)
Microbiology
Students learn about how organisms have adaptations to abiotic factors. Students will grow bacteria on petrie dishes, expose them to different conditions and observe changes.
Organisms
Antibiotic Resistance
Environmental Microbiology

Want to find out more?
If you have any questions, would like to request a free quote, or want to sign up to our newsletter, please contact us.